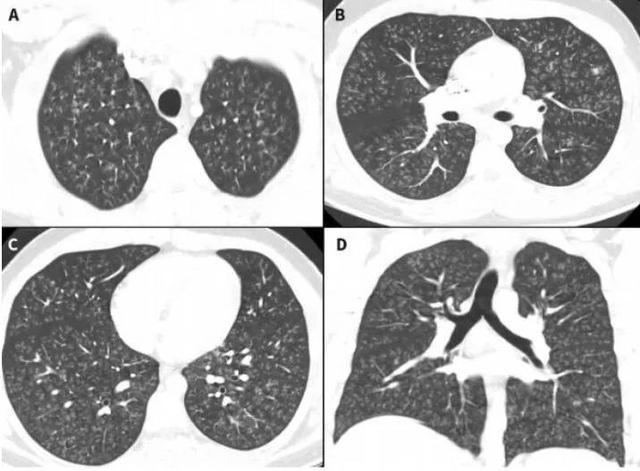
谁干的17岁少年的肺被炸成爆米花

relx爆米花肺

爆米花肺
图片尺寸5120x3840
电子烟对人也有危害
图片尺寸750x563
小野电子烟爆米花肺
图片尺寸600x417
险些造成肺部完全损毁,健康严重受损,症状和"爆米花肺"有些类似,呼吸
图片尺寸543x379
蓝洞辟谣:青年大院电子烟文章系网络资料拼凑,存在多处知识性硬伤
图片尺寸606x1276
谁干的17岁少年的肺被炸成爆米花
图片尺寸640x471
(爆米花肺,图源:网络)6.
图片尺寸1080x605
最耸人听闻的爆米花肺你真的好好了解过吗跟随我们一起揭开这个神秘的
图片尺寸700x300
17岁少年肺被炸成爆米花罪魁祸首也许你家也有
图片尺寸640x413
电子烟与爆米花肺
图片尺寸500x269
造成"爆米花肺"
图片尺寸1080x611
震惊你所吸的电子烟可能让你拥有爆米花肺
图片尺寸607x722
悦刻电子烟有糊味对肺有影响吗
图片尺寸500x496
图26 肺错构瘤患者爆米花样钙化.存在脂肪和无定形钙化(白色箭头).
图片尺寸660x441
典型的像一颗爆米花一样,有确诊价值,如
图片尺寸640x375
17岁少年肺被炸成爆米花这个罪魁祸首你家也许有
图片尺寸475x295
三甲大夫带你认识临床常见病症肺结节的那些事
图片尺寸1280x600
悦刻电子烟1代怎么样价格多少钱悦刻一代产品详解
图片尺寸1920x886
一起来看看传说的爆米花肺到底是怎么形成的
图片尺寸843x1498
指>3厘米且边缘清楚的结节.
图片尺寸640x463